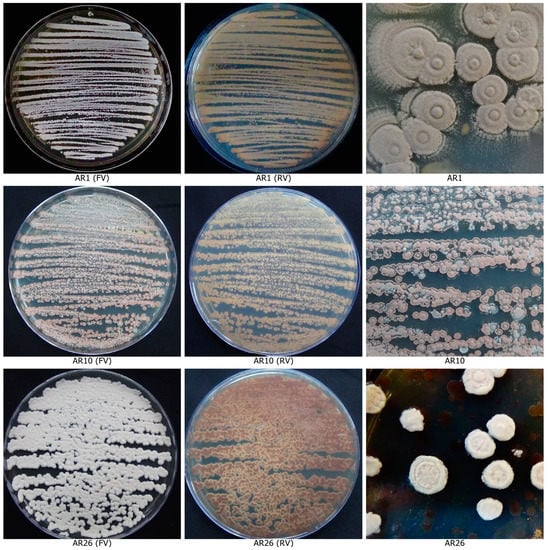

Abstract
Chilli is an universal spice cum solanaceous vegetable crop rich in vitamin A, vitamin C, capsaicin and capsanthin. Its cultivation is highly threatened by fruit rot disease which cause yield loss as high as 80–100% under congenial environment conditions. Currently actinobacteria are considered as eco-friendly alternatives to synthetic fungicides at pre and post-harvest pathosystems. Hence, this research work focuses on the exploitation of rhizospheric, phyllospheric and endophytic actinobacteria associated with chilli plants for their antagonistic activity against fruit rot pathogens viz., Colletotrichum scovillei, Colletotrichum truncatum and Fusarium oxysporum. In vitro bioassays revealed that the actinobacterial isolate AR26 was found to be the most potent antagonist with multifarious biocontrol mechanisms such as production of volatile, non-volatile, thermostable compounds, siderophores, extracellular lytic enzymes. 16S rRNA gene sequence confirmed that the isolate AR26 belongs to Streptomyces tuirus. The results of detached fruit assay revealed that application of liquid bio-formulation of Stretomyces tuirus @ 10 mL/L concentration completely inhibited the development of fruit rot symptoms in pepper fruits compared to methanol extracts. Hence, the present research work have a great scope for evaluating the biocontrol potential of native S. tuirus AR26 against chilli fruit rot disease under field condition as well against a broad spectrum of post-harvest plant pathogens.
1. Introduction
Chilli (Capsicum annuum L.) is one of the most economically important spices cum solanaceous vegetable crops and is grown throughout the world for its green and red ripe fruits. It is a universal spice crop of India and occupies a major share in the Indian economy. In addition to adding pungency, taste, aroma and colour to cuisines, chilli have been used for centuries as medicine with countless health benefits, with antioxidant, anti-mutagenic, anti-carcinogenic, anti-arthritic and anti-inflammatory properties. Chilli fruits are rich in capsaicin, an appetite stimulant, and capsanthin, a pigment that gives its distinctive flavour and colour. Green chilli fruits contain more vitamin C than citrus fruits, whereas red chilli fruits contain more vitamin A than carrots [1,2]. Despite its rich nutritional and economic value, its commercial production is greatly threatened by fruit rot disease caused by complex pathogens including different species of Colletotrichum, Fusarium and Alternaria [3,4,5]. These pathogens extensively damage the fruits and significantly reduce the quality, yield, appearance and marketability of the fruits [6,7]. It is a highly destructive pre- and post-harvest disease which causes yield losses up to 100% under congenial environmental conditions [8,9,10].
Though this disease can be managed with the repeated application of fungicides, pre- and post-harvest application of synthetic fungicides has been curtailed due to the persistence of fungicides on the fruits, which pose a direct risk to consumers and the environment through food chain contamination [11,12,13]. The use of naturally occurring bioactive compounds, especially those derived from antagonistic microorganisms, have been explored as prospective alternatives to synthetic fungicides due to their reduced toxicity and impact on humans and the environment [14,15,16]. Biological control of chilli anthracnose using antagonistic microorganisms or their metabolites is not a new concept, but a sustainable and ecologically acceptable approach in the context of leaving no toxic residues on the produce, safer application methods and ease of delivery, with minimal reliance on chemicals [17,18].
Although different groups of microorganisms have been employed for disease management, several research findings over the past few decades have highlighted the biocontrol potential of actinobacteria against a wide range of plant pathogens [19,20,21] through various mechanisms, including fungal cell-wall lysis, antibiosis, competition for nutrients, induction of host systemic resistance, phytotoxin degradation, plant growth stimulation, nutrient assimilation, rhizosphere competence and mineral availability [22,23,24,25,26,27,28].
Several species of actinobacteria were reported to have strong antagonistic activity against various species of Colletotrichum infecting a variety of crops. Taechowisan et al. [29] reported that Streptomyces spp. SRM1 exhibited antagonistic activity against Colletotrichum musae causing anthracnose in banana. Streptomyces violaceoruber reduced the incidence of chilli anthracnose by inhibiting the spore germination and mycelial growth of Colletotrichum capsici [30]. Streptomyces ambofacines S2 extract completely inhibited the expression of anthracnose symptoms of Colletotrichum gloeosporioides in red pepper fruits [18]. Actinobacteria not only prevent post-harvest pathogenic infection but also prolong the shelf life of a variety of crops without upsetting the natural balance.
A diverse group of actinobacteria inhabit the rhizosphere, phyllosphere and endosphere region of the plant and a subset of these provide a wide range of services and benefits to the plant in terms of suppressing plant diseases, promoting plant growth, increasing crop yield and enhancing soil fertility [31,32,33]. Particularly, when employed to curtail the plant infections, native actinobacterial isolates are more adaptable to their regular niche, have a higher success rate and are more resilient to local environmental challenges than the introduced microbes [34,35]. Furthermore, the introduced microbes must be able to co-habit with the native microbiome in order to provide more benefits to the plants. Hence, precolonization of the host by well adapted native biocontrol agents may prevent the growth and survival of plant pathogens.
The present study was, therefore, undertaken with the following objectives: (1) to isolate native actinobacterial isolates associated with rhizosphere, phyllosphere and surface sterilized tissues of chilli plants; (2) to identify the efficient actinobacterial isolate having antifungal potential against fruit rot pathogens Colletotrichum spp., and Fusarium sp.; (3) to unravel the antifungal mechanisms of potential actinobacterial isolates against fruit rot pathogens under in vitro conditions; (4) to assess the in vivo antifungal efficacy of liquid formulation and soluble metabolites of potential actinobacterial isolates on chilli fruits.
2. Materials and Methods
2.1. Fruit Rot Pathogens
Fruit rot fungal pathogens viz., Colletotrichum scovillei, Colletotrichum truncatum and Fusarium oxysporum were isolated from infected chilli fruits collected from various locations of Tamil Nadu, India. The infected portion of the fruits were cut into small pieces (5 mm) using a sterile blade and surface sterilized with 1% NaOCl4 for 1–2 min followed by 70% ethanol for 30 s and rinsed thrice with sterile distilled water [36]. The surface disinfected fruit pieces were placed onto sterile Potato Dextrose Agar (PDA) medium amended with streptomycin sulphate (0.03 g L−1) and incubated at 28 ± 2 °C for 7 days. Pure cultures of the pathogens were obtained by single hyphal tip method. The stock cultures of the pathogens were maintained as pure cultures on PDA slants at 4 °C.
2.2. Antagonistic Actinobacteria
Rhizosphere actinobacteria were isolated from the rhizosphere soil of healthy chilli plants as described by Anwar et al. [37]. The soil samples were taken from a depth of 10–20 cm and subjected to dry heat pre-treatment for 4 h at 45 °C [38] to diminish the fast growing and abundant soil bacteria that would hinder slow growing actinobacteria [39]. Ten grams (10 g) of pre-treated soil was suspended in 90 mL of sterile distilled water, shaken thoroughly for 1 h at 100 rpm in an orbital shaker and allowed to settle for an hour. Subsequently, samples were serially diluted up to 10−5 dilutions and 1 mL aliquot from 10−3–10−5 dilutions were plated on sterile Starch Casein Agar (SCA) supplemented with 25 µg/mL nalidixic acid and 50 µg/mL nystatin as antibacterial and antifungal agents [40].
Phyllospheric actinobacteria were isolated from the leaf, stem, flower and fruits of healthy chilli plants [41]. Ten grams (10 g) of samples were preheated at 70 °C for 15 min and transferred to 90 mL of 0.85% saline buffer (NaCl) and kept in an orbital shaker at 250 rpm for 30 min at 28 ± 2 °C. The solution thus obtained was subjected to the standard serial dilution pour plate technique on Starch Casein Agar (SCA) supplemented with nalidixic acid (25 µg/mL) and nystatin (50 µg/mL).
The actinobacteria from the surface sterilized plant tissues were isolated as per the procedure described by Li et al. [42]. A five-step procedure was employed for the sterilization of the plant tissues: (i) the tissue segments were surface-sterilized in 0.1% sterile Tween 20 for 1 min, (ii) the samples were sterilized with 5% sodium hypochlorite for 4 min (leaf samples) or 6 min (stem and root samples), (iii) the samples were then rinsed in 2.5% (w/v) sodium thiosulfate for 10 min and washed three times with sterile distilled H2O, followed by (iv) immersing in 70% (v/v) ethanol for 4 min (leaf samples) or 6 min (stem and root samples), and finally (v) the samples were washed with sterile distilled water for a minimum of three times. To validate the successful surface disinfection process, 0.2 mL of water from the final wash was spread onto the isolation medium and incubated at 28 ± 2 °C. One gram of surface-sterilized plant tissues was homogenized in a mortar and pestle with 1 mL of 0.9% saline buffer (w/v). One millilitre of the tissue suspension was serially diluted and 10−3–10−5 dilutions were plated on Starch Casein Agar plates. The plates were incubated at 28 ± 2 °C for 7–10 days. Powdery, bright actinobacterial colonies were purified, suspended in 20% glycerol and stored at −80 °C as stock culture [43].
2.3. In Vitro Antifungal Bioassay
2.3.1. Primary Screening of Actinobacterial Isolates for the Antifungal Activity against Chilli Fruit Rot Pathogens
Fifty-two actinobacterial isolates were screened for their antifungal activity against chilli fruit rot pathogens by dual-culture assay [44]. The test isolates were streaked at one corner of the PDA plates (10 mm from the periphery of a 90 mm diameter Petri dish) and incubated at 28 ± 2 °C for 4 days. After incubation, the 5-day-old pathogen fungal disc was placed opposite to actinobacterial streak (10 mm away from the periphery). Petri dishes without actinobacterial isolates served as the control. All plates were incubated at 28 ± 2 °C for 7 days. All the isolates were tested in triplicate. After incubation, the zone of inhibition was measured and the per cent inhibition of mycelial growth was calculated. The zone of inhibition (ZI) was measured as the diameter of the halo zone (in cm) between the actinobacteria and pathogen colony as and when the pathogen in the control plate covered the entire plate. Per cent inhibition of mycelial growth (PIMG) was determined according to the formula: PIMG = (C − T)/C 100, where C and T are the mycelial growth of pathogenic fungus in the control plate and dual culture plate, respectively. The degree of antifungal activity of various actinobacterial isolates against the tested pathogens were evaluated based on the zone of inhibition (ZI) (in cm) and per cent inhibition of mycelial growth (PIMG) [45]. Based on the zone of inhibition, the antagonistic activity of actinobacterial isolates were grouped into four categories according to Lee and Hwang [46] as: − no inhibition (ZI ≤ 0); + weak inhibition (ZI = 0.1–1.0 cm); ++ moderate inhibition (ZI = 1.01–2 cm); and +++ strong inhibition (ZI ≥ 2 cm).
2.3.2. Secondary Screening for the Antifungal Activity of Actinobacterial Isolates
The antifungal activity of six actinobacterial isolates which exhibited the strongest inhibition against the tested pathogens by dual culture assay was further confirmed by paired culture antibiosis assay as per the protocol of Liotti et al. [47] with slight modification. An 8 mm mycelial disc of the pathogen was placed at the centre of a Petri dish containing PDA medium and the actinobacterial isolate was streaked at equidistance on both sides of the pathogen, about 10 mm from the periphery of Petri dish. A control plate was maintained without actinobacteria. The experiment was replicated thrice. After 7 days of incubation at 28 ± 2 °C, the percentage inhibition of mycelial growth (PIMG) of the pathogen was calculated as per the formula described above.
2.3.3. In Vitro Screening of Actinobacterial Isolates for Production of Extracellular Lytic Enzymes and Siderophore
The actinobacterial isolates were assayed for their biocontrol traits viz., amylase, cellulase, chitinase and protease production by spot inoculating 10 μL of culture in starch agar medium [48], Carboxy Methyl Cellulose (CMC) agar medium [49], colloidal chitin agar medium [50] and skim milk agar medium [51], containing starch, cellulose, colloidal chitin and casein as the respective substrates. Siderophore production was assayed on Chrome Azurol Sulphonate (CAS) agar medium according to the methodology of Sadeghi et al. [52]. The plates were incubated for 5–7 days at 28 ± 2 °C. Three replications were maintained for each actinobacterial isolate.
The amylase activity of the actinobacteria was evaluated by flooding the plate with Lugol’s iodine solution for 30 s. A clear hydrolysis zone around the colonies against the blue background indicated the hydrolysis of starch by the amylase enzyme [53]. Cellulase activity was determined by flooding the plates with 0.1% Congo red solution and counter staining with 1 M NaCl for 15–20 min. The formation of a clear zone around the colony due to the hydrolysis of cellulose indicated a positive result for the production of the cellulase enzyme by the actinobacterial isolates. The isolates positive for chitinolytic and proteolytic activity produced a clear halo zone around the colonies due to the hydrolysis of chitin and casein in the respective media. The formation of a yellow to orange halo around the actinobacterial colonies due to the removal of iron from CAS represented a positive result for the production of siderophore.
2.3.4. Antifungal Activity of Volatile Organic Compounds
The four most active actinobacterial isolates that showed significant positive results for the production of cell wall-degrading enzymes and siderophore were subjected to additional assays on the production of volatile, non-volatile and thermostable compounds. The antifungal activity of volatile organic compounds (VOCs) produced by the actinobacterial isolates was tested against the fruit rot pathogens by the double-sealed plate method [54]. A 90 mm diameter Petri dish bottom containing 15 mL of ISP4 medium was streaked with a loopful of actinobacterial culture. An 8 mm diameter mycelial plug of the pathogen was inoculated in the centre of another Petri dish bottom containing 15 mL of potato dextrose agar medium. A Petri dish “sandwich” was made with the antagonist Petri dish placed over the pathogen plate in such a way that the pathogen plate was at the bottom and antagonist plate was on the top. The sandwiched Petri dish was sealed together with a parafilm without any gaps and incubated at 28 ± 2 °C for 7–10 days. A Petri dish containing ISP4 medium without the antagonist placed over the pathogen plate served as the control. The parafilm-sealed plates ensured no physical contact between the pathogen and antagonist. The experiment was conducted with three replications for each isolate. The rate of inhibition (%) of mycelial growth was calculated as described previously.
2.3.5. Antifungal Activity of Non-Volatile Metabolites
The antifungal activity of non-volatile metabolites in the cell-free culture filtrate of actinobacterial isolates was determined using the seeded agar method [55,56]. Actinobacterial isolates were cultured in a 250 mL conical flask containing 100 mL ISP4 broth and incubated in an orbital shaker at 150 rpm for 7 days at 28 ± 2 °C. Then the culture broth was centrifuged at 10,000 rpm for 15 min at 4 °C. The supernatant obtained was filtered through a 0.22 μm nitrocellulose membrane filter to obtain cell-free culture filtrate and subjected to an antifungal assay. The filtrate was mixed with warm PDA (25%) and plated in a sterile Petri dish. Finally, an 8 mm mycelial disc of the pathogen was placed at the centre of the seeded PDA medium in the Petri dish. The pathogen growth on the Petri dish without the cell-free culture filtrate served as the control. The plates were incubated at 28 ± 2 °C until the mycelial disc in the control plate completely covers the plate. Three replicates were maintained for each isolate. Per cent inhibition (PI) of mycelial growth was calculated as described previously.
2.3.6. Antifungal Activity of Thermostable Compounds
The actinobacterial isolates were cultured in 100 mL ISP4 broth in a 250 mL conical flask with constant agitation in an orbital shaker (150 rpm) for 7 days at 28 ± 2 °C. The actinobacterial cells were harvested by centrifugation at 10,000 rpm for 15 min. Twenty-five millilitres of the supernatant were transferred to a conical flask containing 75 mL PDA medium and sterilized at 121 °C for 20 min. The actinobacterial metabolite-amended sterile medium was plated into Petri dish and a 9 mm mycelial disc of the tested pathogen was placed at the centre of solidified medium. The pathogen growth on PDA medium without actinobacterial metabolite served as the control. The Petri dishes were incubated at room temperature for 7 days and the Per cent Inhibition (PI) of mycelial growth of the pathogen was assessed as per the formula described above.
2.3.7. Assessment of In Vitro Antifungal Traits
Among the six isolates, the best isolate with the highest antagonistic potential was selected based on a bonitur scale as described by Passari et al. [57] and El-Sayed et al. [58]. In this scale, points were given for each in vitro antifungal trait and the maximum bonitur score is 24 points. The per cent inhibition of mycelial growth (PIMG) was evaluated as follows: if PIMG is 30–54.9% = 1 point; 55–74.9% = 2 points; 75–95% = 3 points. Lytic enzyme production was evaluated with 1 point and siderophore with 2 points each.
2.4. Scanning Electron Microscopy (SEM)
The interaction of the actinobacterial isolate AR26 which exhibited strong antifungal activity against the pathogens in the dual culture plate was documented by Scanning Electron Microscope (SEM) (Model: FAI QUANTA 250, Czech Republic) at 15 KV [59]. Mycelial discs (5 mm) of the pathogen from the periphery of inhibition zone in the dual culture plate as well as in the control plate were cut with a sterile scalpel and transferred to perforated capsules and fixed in 1.5% glutaraldehyde in phosphate buffer for 4 h [60]. Then, the specimens were washed with 0.2 M sodium cacodylate buffer (pH 6.2) and dehydrated with an increasing concentration of ethanol washes from 0–100% at 10 min intervals (0%, 30%, 50%, 70%, 80%, 90% and 100%). Later the specimens were mounted on aluminium stubs using conductive double-sided carbon tape. The stubs were then lyophilized, and sputter coated with gold (5 nm thickness). Finally, any morphological changes of the pathogen mycelium in the dual culture plate as well as in the control plate were examined under scanning electron microscope.
2.5. Molecular Characterization of Actinobacterial Isolates
The genomic DNA of the actinobacterial isolate was extracted from the spore masses using the Cetyl Trimethyl Ammonium Bromide (CTAB) method [61]. The 1.5 kb full length 16S rRNA gene of actinobacteria was amplified by Polymerase Chain reaction (PCR) with a forward primer 27F (5′ AGAGTTTGATCCTGGCTCAG-3′) and reverse primer 1492R (5′-GGTTACCTTGTTACGACTT-3′) [62]. The PCR amplification was performed with a 25 μL reaction mixture which contained 10 μL of master mix, 1 μL of bacterial genomic DNA at a concentration of 20 ng, 1 μL of each primer at a concentration of 10 pM and 12 μL of sterilized deionized water. The PCR amplification conditions included an initial denaturation at 94 °C for 5 min, 35 cycles of denaturation at 94 °C for 1 min, annealing at 55 °C for 1 min, extension at 72 °C for 40 s and final extension at 72 °C for 10 min. The PCR amplified products were visualized on 1% agarose gel with a UV transilluminator and photographed using the gel documentation system and sequenced at Biokart India Pvt. Ltd., Bangalore, India. The sequence similarities were determined by BLAST analysis (Basic Local Alignment Search Tool) (BLAST, (https://www.ncbi.nlm.nih.gov) (accessed on 27 November 2022) and submitted in GenBank. The most homologous sequences showing the highest similarity were retrieved from the NCBI GenBank database and multiple sequences were aligned using the ClustalW algorithm. A phylogenetic tree was constructed with closely related nucleotide sequences using the Neighbour-Joining (NJ) method [63] using MEGA (Molecular Evolutionary Genetics Analysis) 11 software [64] with bootstrap values of 1000. Evolutionary distances were calculated using the maximum combined likelihood method and are given in units of the number of base substitutions per site.
2.6. Antifungal Bioassay of Liquid Formulation of Actinobacterial Isolate on Chilli Fruits
The antifungal activity of actinobacterial isolate AR26 on green chilli fruits was determined as per the antifungal bioassay of Liottia et al. [47]. Fresh fruits of the chilli hybrid “Ganga” of uniform size and maturity without wounds, scars and rots on their surface were surface sterilized as described previously. The surface sterilized green chilli fruits were wounded to the depth of 1 mm with a sterile needle and subjected to following treatments. (i) healthy control: chilli fruits were inoculated with 20 μL of sterile distilled water, (ii) pathogen-inoculated control: chilli fruits were inoculated with 6 mm mycelial disc of pathogen culture, (iii) antagonist inoculated control: chilli fruits were inoculated with 20 μL of liquid formulation of S. tuirus AR26 at10 mL/L containing 9 × 108 CFU/mL, (iv) chilli fruits were first inoculated with 20 μL of liquid formulation of S. tuirus at 5 mL/L and after an hour of incubation, 6 mm mycelial disc of respective pathogens were placed over it, (v) chilli fruits were first inoculated with 20 μL of liquid formulation of S. tuirus at 10 mL/L and 6 mm mycelial disc of respective pathogens were placed over it.
Inoculated fruits of each treatment were placed in separate glass Petri dishes, sealed with parafilm and incubated at 28 ± 2 °C for 7 days. The experiment was conducted statistically as a completely randomized design (CRD) in three replicates of five fruits each. The progress of the symptom on the fruits was measured as the lesion diameter after seven days of incubation. The percentage of inhibition of fruit rot symptom and disease incidence was calculated as per the formula given below. Per cent disease reduction = [(D − d) × 100]/D, where D is the lesion diameter in pathogen-inoculated control fruits, and d is the lesion diameter in actinobacteria and pathogen co-inoculated fruits.
Disease incidence = (Number of diseased chili fruits/Total number of chili fruits) × 100.
2.7. Antifungal Bioassay of Soluble Metabolites of Actinobacterial Isolate on Chilli Fruits
This assay was conducted to differentiate whether the antifungal activity was mediated by the presence of actinobacterial culture or by its metabolites. The soluble metabolites produced by the isolate AR26 in the dual culture plate in PDA medium were extracted from the zone of inhibition by excising the PDA medium from the inhibition zone using a sterile scalpel. Excised PDA medium was blended with HPLC-grade acetonitrile in a 1:4 ratio (5 g agar in 20 mL of HPLC grade acetonitrile). The mixture was incubated overnight at 28 ± 2 °C in an orbital shaker at 150 rpm. The homogenised samples were subjected to 10 min centrifugation at 10,000 rpm, and then filtered through Whatman No.1 filter paper to separate the agar particles and supernatant. The supernatant was dried in a vacuum flash evaporator (Roteva Equitron Make). After discarding the eluent, the final product was diluted in 1 mL of HPLC-grade methanol [65]. The extract obtained was tested for its ability to control chilli fruit rot pathogens. The assay was performed as described above with four treatments, using 20 μL of methanol extract of S. tuirus AR26 for treatments and 20 μL of methanol alone for control.
2.8. Statistical Analysis
The data was subjected to a single factor test of significance (ANOVA) using the analytical software SPSS version 16.0. Significant differences between the average values of each treatment (p ≤ 0.05) were determined using critical difference.
3. Results
3.1. Primary Screening for Antifungal Activity of Actinobacterial Isolates
In this study, 52 actinobacterial isolates obtained from rhizospheric (26), phyllospheric (16) and surface sterilized plant tissues (10) of chilli plants were screened for their antagonistic potential against chilli fruit rot pathogens viz., C. scovillei, C. truncatum and F. oxysporum by dual culture technique. About 19.2% of the rhizospheric isolates, 12.5% of phyllospheric isolates and 10.0% of the endophytic isolates exhibited strong antifungal activity against C. scovillei, whereas 15.4% of the rhizospheric isolates and 12.5% of the phyllospheric isolates and again 10.0 % of endophytic isolates showed antifungal activity against C. truncatum. With regard to F. oxysporum, 23.1% of rhizospheric, 12.5% of phyllospheric isolates and 10.0% of endophytic isolates showed strong antagonistic activity. Thirty-eight (73.07%) out of 52 isolates inhibited the mycelial growth of at least one out of the three pathogens with varying degrees of inhibitory action, ranging from 4.82% to 67.90% (weak to strong inhibition) (Supplementary Table S1 and Figure 1). Six isolates designated as AR1, AR10, AR26, AL5, AL7, and AFE2 strongly inhibited the growth of all three pathogens (Figure 2) with an inhibition zone (ZI) greater than 2 cm. Isolate AR26 was found to be significantly superior to other isolates, with the highest mycelial growth inhibition of 67.90%, 63.21%, and 60.37% and inhibition zones of 3.2 cm, 2.8 cm, and 2.7 cm respectively for C. scovillei, C. truncatum, and F. oxysporum, followed by the isolate AR10 (Figure 3).
Figure 1.
Heat map showing the in vitro antagonism of actinobacterial isolates against chilli fruit rot pathogens as represented by zone of inhibition.
Figure 2.
Venn diagram representing the actinobacterial isolates exhibiting strong antagonism against fruit rot pathogens.
Figure 3.
Antifungal activity of actinobacterial isolates against chilli fruit rot pathogens. (A) Control C. scovillei (D) Control C. truncatum (G) Control F. oxysporum. Antifungal activity of actinobacterial isolate AR26 against (B) C. scovillei (E) C. truncatum (H) F. oxysporum. Antifungal activity of actinobacterial isolate AR10 against (C) C. scovillei (F) C. truncatum (I) F. oxysporum.
3.2. Secondary Screening for the Antifungal Activity of Actinobacterial Isolates and Scanning Electron Microscopic Assay
The six isolates (Figure 4) which showed the strongest antagonism against the three pathogens were further subjected to secondary screening by paired culture antibiosis to further confirm their antagonistic ability against C. scovillei, C. truncatum and F. oxysporum. The results of this assay indicated that all six isolates were capable of inhibiting the growth of C. scovillei, C. truncatum and F. oxysporum. The isolate AR26 was found to be significantly superior to other isolates in inhibiting mycelial growth of C. scovillei (59.63%), C. truncatum (61.18%) and F. oxysporum (63.58%), respectively followed by the isolate AR10 (Supplementary Figure S1). The isolate AFE2 recorded the lowest percentage of mycelial growth inhibition of the tested pathogens, relative to the other five isolates. Scanning Electron Microscopy (SEM) observations indicated a clear evidence for antifungal activity of isolate AR26 against C. scovillei, C. truncatum and F. oxysporum. The antifungal activity was observed as distinct morphological deformities in pathogen hyphae in the presence of antagonist and hyphae were found to be twisted and shrunk in C. scovillei, disintegrated in C. truncatum, aggregated into clusters in F. oxysporum with reduction in mycelial mat (Figure 5). In contrast, the hyphae in the control plate were dense, intact with regular structure.
Figure 4.
Actinobacterial isolates with potent antagonistic activity against fruit rot pathogens.
Figure 5.
Scanning Electron Micrographs showing the interaction of antagonist. S. tuirus AR26 with C. scovillei, C. truncatum and F. oxysporum; (A) intact mycelium of C. scovillei in the absence of antagonist; (B) twisted and shrunken hyphae of C. scovillei in the presence of antagonist; (C) mycelium of C. truncatum in absence of antagonist; (D) distorted hyphae of C. truncatum in the presence of antagonist; (E) dense and intact mycelium of F. oxysporum in absence of antagonist; (F) aggregated hyphae of F. oxysporum in presence of antagonist.
3.3. Screening for the Production of Extracellular Lytic Enzymes and Siderophore by the Antagonists
All six actinobacterial isolates were able to produce at least 4 out of 5 hydrolytic enzymes to different degrees. All the isolates tested positive for amylase and cellulase. The isolates AR10, AR26 and AL7 produced siderophore and AR1, AR10, AR26 and AL7 recorded chitinase activity. The isolates AL5 and AFE2 produced protease while all other isolates tested negative for protease activity. The results revealed that the isolates AR10, AR26 and AL7 were positive for siderophore, amylase, cellulase, and chitinase. The isolate AR26 was the most potent antagonist to produce prominently siderophore, cellulase and chitinase (Supplementary Figures S2–S7).
3.4. Antifungal Activity of Volatile, Non-Volatile and Thermostable Compounds
All of the four isolates AR10, AR26, AL5 and AL7 apparently produced volatile, non-volatile and thermostable compounds, and significant differences in the antifungal activity against the tested pathogens were observed among the isolates (Figure 6). The volatile compounds of isolates AR10, AR26, and AL5 were found to be more effective than non-volatile and thermostable compounds. The volatile organic compounds of isolate AR26 exhibited the maximum inhibitory effect against C. scovillei (77.04%), C. truncatum (72.63%) and F. oxysporum (69.53%). The thermostable compound of AR26 exhibited the strongest inhibitory action against F. oxysporum, followed by AR10.
Figure 6.
Antifungal activity of volatile, non-volatile and thermostable compounds. Error bars represent the standard deviation of the data set.
3.5. Assessment of In Vitro Antifungal Traits
The results of the assessment for in vitro antifungal traits revealed that out of the six isolates screened, rhizospheric isolate AR26 showed the highest assessment value of 17 points followed by the isolate AR10 with 15 points. Hence, the actinobacterial isolate AR26 was selected as the most efficient antagonist for further studies (Table 1).
Table 1.
Actinobacterial isolates for their ability to function as antagonist with various antifungal mechanisms.
3.6. Molecular Confirmation of Actinobacterial Isolates
The results of the 16S rRNA sequence analysis of the actinobacterial isolates revealed that five isolates were closely affiliated to the genus Streptomyces. Isolates AR1, AR10, AL5, AR26 and AL7 exhibited the highest similarity with Streptomyces rochei, Streptomyces deccanensis, Streptomyces azureus, Streptomyces tuirus, and S. geysiriensis, respectively (Table 2). Phylogenetic analysis revealed that the isolates under current study formed five different clades (highlighted in red) and were supported with good bootstrap values (Figure 7). Isolate AR10 formed a distinct clade A with S. deccanensis, AL5 formed clade B with S. azureus, AR26 formed clade C with S. tuirus, AR1 formed clade D with S. rochei, and AL7 formed clade E with S. geysiriensis, with Pseudomonas fluorescens as the out group.
Table 2.
16S ribosomal RNA partial sequence analysis of actinobacterial isolates and their closest BLASTN matches with NCBI database supplementary.
Figure 7.
Phylogenetic tree representing the evolutionary relationships of five potent antagonistic actinobacterial isolates isolated from chilli plants. Neighbour joining (NJ) phylogenetic tree constructed from 16S rRNA sequences shows the position of five potent actinobacterial isolates (highlighted in red) and all isolates belong to the genera Streptomyces. Bootstrap values (expressed as percentages of 1000 replications) are shown at the nodes. Pseudomonas fluorescens 1-42 (MK88064) was used as an outgroup. GenBank accession numbers are given in parenthesis.
3.7. Biocontrol Potential of Liquid Formulation and Methanol Extract of S. tuirus AR26
Healthy chilli fruits inoculated with C. scovillei, C. truncatum, F. oxysporum and the co-inoculation of three pathogens produced typical fruit rot symptoms in the form of lesions of up to 2.5, 2.2, 2.6 and 2.9 cm, respectively, seven days after inoculation with the pathogens. Fruits that were not inoculated with the pathogens (healthy control) did not develop fruit rot symptoms, indicating that C. scovillei, C. truncatum and F. oxysporum were the causative agent of the anthracnose disease. Chilli fruits inoculated with the liquid formulation of S. tuirus AR26 caused no symptoms or damage to the fruits, indicating its non-pathogenic nature and biocontrol ability (Table 3). The liquid formulation of S. tuirus AR26 at both the concentrations 5 mL/L and 10 mL/L caused significant reductions in disease symptom when compared to the pathogen-inoculated control. Application of the liquid formulation of S. tuirus AR26 at 10 mL/L completely (100%) suppressed the fruit rot lesions caused by C. truncatum, F. oxysporum and Cscovillei + C. truncatum + F. oxysporum. C. scovillei inoculated fruits recorded 87.9% disease reduction with a corresponding lesion size of 0.30 cm when compared to the C. scovillei inoculated control (2.48 cm) (Figure 8). The liquid formulation at 5 mL/L concentration reduced the lesion size by 70.85%, 82.68%, 67.32% and 77.08%, respectively for C. scovillei, C. truncatum, F. oxysporum and the co-inoculation of all the three pathogens with corresponding lesion size of 0.73 cm, 0.38 cm, 0.85 cm and 0.63 cm. Irrespective of pathogens, the metabolites in the methanol extract of antagonist also had significant inhibitory effect on the suppression of fruit rot lesions on chilli fruits compared to the pathogen-inoculated control (Table 4). However, the percentage inhibition of the fruit rot lesion by the antagonist metabolites was significantly lower than the active culture formulation of S. tuirus AR26. Antagonist metabolites reduced the lesions up to 70.10%, 62.45%, 53.08% and 44.85% caused by C. truncatum, C. scoviellei, F. oxysporum and co-infection of three pathogens, respectively.
Table 3.
Antifungal efficacy of liquid formulation of Streptomyces tuirus AR26 against chilli fruit rot pathogens.

Figure 8.
Antifungal efficacy of liquid formulation and methanol extract of S. tuirus AR26 against chilli fruit rot pathogens. (A) Fruits inoculated with sterile distilled water; (B) fruits inoculated with methanol alone; (C) fruits inoculated with liquid formulation of S. tuirus AR26 at 10 mL/L; (D) fruits inoculated with C. scovillei and methanol extract of S. tuirus AR26; (E) fruits inoculated with C. scovillei alone; (F) fruits inoculated with C. scovillei and liquid formulation of S. tuirus AR26 at 10 mL/L; (G) fruits inoculated with C. truncatum and methanol extract of S. tuirus AR26; (H) fruits inoculated with C. truncatum alone; (I) fruits inoculated with C. truncatum and liquid formulation of S. tuirus AR26 at 10 mL/L; (J) fruits inoculated with F. oxysporum and methanol extract of S. tuirus AR26; (K) fruits inoculated with F.oxysporum alone; (L) fruits inoculated with F. oxysporum and liquid formulation of S. tuirus AR26 at 10 mL/L AR26; (M) fruits inoculated with C. scovillei, C. truncatum, F. oxysporum and methanol extract of S. tuirus AR26; (N) fruits inoculated with C. scovillei, C. truncatum, F. oxysporum alone; (O) fruits inoculated with C. scovillei, C. truncatum, F. oxysporum and liquid formulation of S. tuirus AR26 at 10 mL/L.
Table 4.
In vivo antifungal efficacy of methanol extract of S. tuirus AR26 against chilli fruit rot pathogens.
4. Discussion
The use of synthetic fungicides is a common practice among farmers for many decades for the management of chilli fruit rot disease; however, this can cause several ill effects to the environment and living creatures. The most urgent and necessary activity of human society is to eliminate the use of fungicides in food crops [66] like chilli which are directly consumed by people. Hence, protecting crops with safe biocontrol agents will not only address concerns about fungicide residues in fresh and processed products, but also increase the export value of fungicide-free food products in domestic as well as world markets. Furthermore, antagonistic microbe–plant interactions reduce the dependence on chemical pesticides by upto 20% [67]. Native actinobacteria adopting a dual role as a biocontrol agent and biofertilizer is a more sustainable, promising and versatile candidate towards the eco-friendly management of plant disease with multiple benefits to society and the ecosystem as a whole.
Hence, in the present study, around 52 actinobacterial isolates were screened for their antagonistic activity against the chilli fruit rot pathogens. Among which, six isolates AR1, AR10, AR26, AL5, AL7 and AFE2 exerted strong antifungal activity against all three pathogens with an inhibition zone of >2 cm and belonged to the genus Streptomyces. It was evidenced from previous literature that several species of Streptomyces have emerged as biocontrol agents that are safe alternatives to synthetic fungicides for the management of phytopathogens [68,69]. There is ample scientific evidence indicating the successful interaction of various Streptomyces spp. with chilli plants to curtail the infection of fruit rot pathogens both at pre- and post-harvest levels. Shahbazi et al. [70] reported that Streptomyces rochei strain P42 displayed the highest inhibitory activity against C. acutatum, C. capsici and C. gloeosporioides. S. griseocarneus R132 inhibited the development of anthracnose symptom in chilli fruits [47], and likewise the application of S. violaceoruber fermentation broth reduced the incidence of the chilli anthracnose under greenhouse conditions [30].
The results of the present study also revealed that a higher proportion of native rhizospheric actinobacteria exert strong antagonistic activity against C. scovillei and C. truncatum compared to phyllospheric and endophytic isolates. Similar results were also highlighted by Shahbazi et al. [70], who reported that out of 66 native rhizosphere strains of streptomycetes, 16 strains showed very strong to moderate inhibition against C. acutatum, C. capsici and C. gloeosporioides. Many researchers have reported that diverse species of actinobacteria are recognized to play a crucial function in the rhizosphere by suppressing pathogenic species, as well as promoting the growth and multiplication of beneficial microbes. Streptomyces is one of the most dominant and promising biocontrol bacterial genera of plant diseases which efficiently colonise the plant rhizosphere and are known to produce over two-third of antibiotics with the ability to inhibit a wide range of phytopathogens [71,72]. Hyder et al. [73] stated that eight native rhizospheric bacterial isolates obtained from chilli plants were found to exert antifungal activity against damping pathogen Phytophthora capsici in vitro and in vivo.
Based on the dual culture and paired antibiosis assay, the actinobacterial isolate AR26 obtained from chilli rhizosphere, which was subsequently identified as Streptomyces tuirus, was found to be the most effective isolate in inhibiting the mycelial growth of all the three tested pathogens. This finding is in accordance with the results of Chaudhry [74] who reported that S. tuirus strongly inhibited carrot cavity spot pathogen Pythium violae including various other pathogens such as Phytophthora spinosum, Phytopythium helicoides, Fusarium oxysporum, Fusarium falciforme, Fusarium solani, Sclerotium rolfsii, and Sclerotinia sclerotiorum. Scanning electron micrographs of the interaction of S. tuirus with fruit rot pathogens in the dual culture plate revealed mycelial deformities like shrinkage, distortion and aggregation of C. scovillei, C. truncatum and F. oxysporum hyphae, in contrast to dense, smooth and regular mycelium in the control plate. Xu et al. [75] also observed severe morphological and internal abnormalities such as the shrinkage and aggregation of Magnaporthe oryzae hyphae when treated with the culture filtrate of rice endophyte Streptomyces hygroscopicus OsiSh-2.
S. tuirus also exhibited positive results for most of the antifungal bioassays under study. It is the most potent antagonist to produce almost all the tested extracellular hydrolytic enzymes, most prominently cellulase and chitinase which are reported to be the important hydrolytic enzymes responsible for the biocontrol ability of an antagonist. High chitinase-producing strains are more antagonistic to fruit-rotting pathogens compared to low-chitinase-producing strains [76]. Jha and Modi [77] and Bhattacharyya et al. [78] pointed out that the genus Streptomyces is an efficient producer of various lytic enzymes, which plays an important role in the biological control of plant diseases by degrading the cell wall of phytopathogenic fungi made up of chitins and glucans. It is also evident from the earlier reports that Streptomyces spp. are significantly responsible for the suppression of plant diseases through the production of chitinase, glucanase [40] and protease [79]. Shahbazi et al. [70] stated that the production of hydrolytic enzymes, especially chitinases, can be considered as a potential antagonistic mechanism against chilli anthracnose pathogens. Therefore, the production of these enzymes will help to select potential actinobacterial isolates for the biological control of the tested pathogens.
S. tuirus AR26 is also a highly efficient synthesizer of siderophore which is considered to be one of the most important mechanisms for the biocontrol of plant pathogens [80], in which the antagonist inhibits pathogen growth by depriving it of the available iron in the environment [81]. Hence, it is possible that the siderophore-producing ability of S. tuirus AR26 might also have contributed to the suppression of mycelial growth of all the tested pathogens. It is similar to the finding of Liotti et al. [47] who reported the possible role of siderophore of S. griseocarneus R132 in the biocontrol of F. oxysporum in chilli.
Volatile, non-volatile and thermostable compounds of the S. tuirus isolate AR26 also reported significant antifungal activity, particularly volatile organic compounds, which recorded the maximum antifungal activity against the fruit rot pathogens. Many Streptomyces spp. were reported to produce various volatile compounds that were effective against the anthracnose disease in various crops [82]. The volatile compounds from Streptomyces philanthi RM-1-138 and Streptomyces spp. are highly potent for the biocontrol of chili anthracnose caused by C. gloeosporioides PSU-NY8 [14] and cucumber anthracnose caused by C. orbiculare [83] respectively in the post- harvest pathosystem. Metabolites produced by Streptomyces include bioactive compounds such as macrolide, benzoquinones, aminoglycosides, polyenes, and nucleoside antibiotics that are involved in the suppression of various phytopathogens [84,85].
The results of detached fruit assay revealed that application of active antagonists in the form of a liquid bio-formulation was found to be most effective against all the three pathogens compared to methanol extracts. The active culture of the antagonist S. tuirus AR26 in the liquid bio formulation caused a significant reduction in the expression of fruit rot symptom, ranging from 87.9% to as high as 100%. It completely suppressed the expression of symptoms caused by C. truncatum, F. oxysporum and C. scovillei + C. truncatum, F. oxysporum in chilli fruits, which is approximately 30%, 50% and 55% higher than the suppression by the methanol extract. Our finding is in line with the research findings of Sadeghian et al. [50] who also reported that active antagonists as practical formulations seem more effective compared to crude extracts against the bitter rot of apple fruits caused by C. gloeosporioides.
Therefore, the inhibition of fruit rot pathogens observed in this study might be due to the antagonistic potential of S. tuirus AR26 through the production of antifungal compounds, siderophores, chitinase or through the synergistic action of all these mechanisms. It has been documented in earlier findings that the antifungal ability of actinobacteria might be due to the synergistic activity of two or more antagonistic mechanisms. Furthermore, Evangelista-Martínez [86] also reported that the Streptomyces sp. CACIA-1.46HGO strain inhibited the hyphal growth of many fungal plant pathogens by the production of secondary metabolites, extracellular enzymes and probably by the combined effect of these mechanisms. It is well understood from the findings of Yasmin et al. [87] who reported that the antagonistic activity of Pseudomonas spp. E227, E233, Rh323, Serratia sp. Rh269 and Bacillus sp. might be due to the production of siderophores, lytic enzymes and HCN or the synergistic interaction of these two or with other metabolites.
5. Conclusions
The management of chilli fruit rot disease still continues to be the focus of intensive research. Though there are several ways of managing this disease, none of the methods were found to be completely successful when applied alone. Hence a preliminary attempt was made to screen the antifungal activity of native actinobacteria against fruit rot pathogens under in vitro conditions. Current results confirmed the potentiality of native actinobacterial isolate S.tuirus AR26 to be exploited as a biointensive component under an integrated disease management strategy. The actinobacteria S. tuirus AR26 exhibited multifarious biocontrol mechanisms such as the production of volatile, non-volatile and thermostable compounds, competition for iron through the synthesis of siderophores, and production of extracellular lytic enzymes such as chitinase and cellulases. Hence, S. tuirus AR26 has a great scope for evaluating its biocontrol potential against chilli fruit rot disease under field conditions as well against a broad spectrum of post-harvest plant pathogens. Larger investigations in the future will demonstrate such possibilities. As farmers become increasingly aware of the concept of sustainable agriculture and organic farming, use of this actinobacteria based bio-formulation will definitely address concerns about ecologically sustainable and socially acceptable long-term solutions to tackle notorious fruit rot pathogens.
Supplementary Materials
The following are available online at https://www.mdpi.com/article/10.3390/life13020426/s1, Figure S1: Paired antibiosis assay for antifungal activity of actinobacterial isolates against chilli fruit rot pathogens; Figure S2: Relative ability of actinobacterial isolates to produce siderophore and extracellular hydrolytic enzymes; Figure S3: Screening of actinobacterial isolates for amylase activity; Figure S4: Screening of actinobacterial isolates for cellulase activity; Figure S5: Screening of actinobacterial isolates for chitinase activity; Figure S6: Screening of actinobacterial isolates for protease activity; Figure S7: Screening of actinobacterial isolates for siderophore production; Table S1: In vitro antifungal activity of actinobacterial isolates against chilli fruit rot pathogens.
Author Contributions
Conceptualization, R.R., K.P., L.R., R.A., L.P., T.R. and G.K.; methodology, R.R., L.R., K.P., R.A. and L.P.; validation, R.R., K.P., L.R. and R.A.; formal analysis, R.R.; investigation, R.R.; K.P. and L.R.; resources, K.P., L.R., R.A., L.P., T.R. and G.K.; data curation, R.R.; writing—original draft preparation, R.R.; writing—review and editing, R.R., K.P. and R.A.; visualization, R.R., K.P. and L.R.; supervision, K.P.; project administration, K.P. All authors have read and agreed to the published version of the manuscript.
Funding
This research received no external funding.
Institutional Review Board Statement
Not applicable.
Informed Consent Statement
Not applicable.
Data Availability Statement
The dataset supporting the conclusions of this article are included within the article and its additional files.
Conflicts of Interest
The authors declare no conflict of interest.
References
- Osuna, G.; Jorge, A.; Wall, M.M.; Waddell, C.A. Endogenous levels of tocopherols and ascorbic acid during fruit ripening of New Mexican-type chile (Capsicum annuum L.) cultivars. J. Agric. Food Chem. 1998, 46, 5093–5096. [Google Scholar] [CrossRef]
- Than, P.; Prihastuti, H.; Phoulivong, S.; Taylor, P.W.; Hyde, K.D. Chilli anthracnose disease caused by Colletotrichum species. J. Zhejiang Univ. Sci. B 2008, 9, 764–778. [Google Scholar] [CrossRef]
- Dwivedi, N.; Tirkey, D.S.; Katoch, S.; Prasad, L. Evaluation of resistance against anthracnose (Colletotrichum capsici and C. gloeosporioides) in chilli landraces collected from the northeastern region of India. Plant Genet. Resour. 2021, 19, 538–544. [Google Scholar] [CrossRef]
- Machenahalli, S.; Nargund, V.; Patil, S. Quick detection and diagnosis of chilli fruit rot pathogens. Vegetos 2014, 27, 188–191. [Google Scholar] [CrossRef]
- Parey, M.A.; Razdan, V.; Sofi, T. Comparative study of different fungi associated with fruit rot of chilli and screening of chilli germplasm against Colletotrichum capsici. Int. J. Agric. Crop Sci. 2013, 5, 723. [Google Scholar]
- Liu, F.; Tang, G.; Zheng, X.; Li, Y.; Sun, X.; Qi, X.; Chang, X. Molecular and phenotypic characterization of Colletotrichum species associated with anthracnose disease in peppers from Sichuan Province, China. Sci. Rep. 2016, 6, 32761. [Google Scholar] [CrossRef]
- Machenahalli, S.; Nargund, V.; Byadgi, A.; Hegde, Y. Integrated management of die-back and fruit rot of Chilli (Capsicum annuum L.). Vegetos 2016, 29, 1000122. [Google Scholar] [CrossRef]
- Garg, R.; Loganathan, M.; Saha, S.; Roy, B. Chilli Anthracnose: A review of causal organism, resistance source and mapping of gene. In Microbial Diversity and Biotechnology in Food Security; Springer: New Delhi, India, 2014; pp. 589–610. [Google Scholar]
- Maharaj, A.; Rampersad, S.N. Genetic differentiation of Colletotrichum gloeosporioides and C. truncatum associated with anthracnose disease of papaya (Carica papaya L.) and bell pepper (Capsium annuum L.) based on ITS PCR-RFLP fingerprinting. Mol. Biotechnol. 2012, 50, 237–249. [Google Scholar] [CrossRef] [PubMed]
- Saxena, A.; Raghuwanshi, R.; Gupta, V.K.; Singh, H.B. Chilli anthracnose: The epidemiology and management. Front. Microbiol. 2016, 7, 1527. [Google Scholar] [CrossRef]
- Chanchaichaovivat, A.; Panijpan, B.; Ruenwongsa, P. Putative modes of action of Pichia guilliermondii strain R13 in controlling chilli anthracnose after harvest. Biol. Control 2008, 47, 207–215. [Google Scholar] [CrossRef]
- Chinthagunta, L.; Zachariah, S. Evaluation of biological, chemical and IDM modules for the management of anthracnose and die-back of chilli. J. Mycol. Plant Pathol. 2012, 42, 435–438. [Google Scholar]
- Unnikrishnan, V.; Nath, B. Hazardous chemicals in foods. Indian J. Dairy Biosci. 2000, 11, 155–158. [Google Scholar]
- Boukaew, S.; Petlamul, W.; Bunkrongcheap, R.; Chookaew, T.; Kabbua, T.; Thippated, A.; Prasertsan, P. Fumigant activity of volatile compounds of Streptomyces philanthi RM-1-138 and pure chemicals (acetophenone and phenylethyl alcohol) against anthracnose pathogen in postharvest chili fruit. Crop Prot. 2018, 103, 1–8. [Google Scholar] [CrossRef]
- Ruangwong, O.-U.; Pornsuriya, C.; Pitija, K.; Sunpapao, A. Biocontrol mechanisms of Trichoderma koningiopsis PSU3-2 against postharvest anthracnose of chili pepper. J. Fungi 2021, 7, 276. [Google Scholar] [CrossRef]
- Tripathi, P.; Dubey, N. Exploitation of natural products as an alternative strategy to control postharvest fungal rotting of fruit and vegetables. Postharvest Biol. Technol. 2004, 32, 235–245. [Google Scholar] [CrossRef]
- Gowtham, H.; Murali, M.; Singh, S.B.; Lakshmeesha, T.; Murthy, K.N.; Amruthesh, K.; Niranjana, S. Plant growth promoting rhizobacteria-Bacillus amyloliquefaciens improves plant growth and induces resistance in chilli against anthracnose disease. Biol. Control 2018, 126, 209–217. [Google Scholar] [CrossRef]
- Heng, J.L.S.; Shah, U.K.; Rahman, N.A.A.; Shaari, K.; Hamzah, H. Streptomyces ambofaciens S2—A potential biological control agent for Colletotrichum gleosporioides the causal agent for anthracnose in red chilli fruits. J. Plant Pathol. Microbiol. 2015, S1, 6. [Google Scholar] [CrossRef]
- Ebrahimi-Zarandi, M.; Bonjar, G.H.S.; Riseh, R.S.; El-Shetehy, M.; Saadoun, I.; Barka, E.A. Exploring two Streptomyces species to control Rhizoctonia solani in tomato. Agronomy 2021, 11, 1384. [Google Scholar] [CrossRef]
- Wang, C.; Wang, Z.; Qiao, X.; Li, Z.; Li, F.; Chen, M.; Cui, H. Antifungal activity of volatile organic compounds from Streptomyces alboflavus TD-1. FEMS Microbiol. Lett. 2013, 341, 45–51. [Google Scholar] [CrossRef]
- Wu, P.-H.; Tsay, T.-T.; Chen, P. Evaluation of Streptomyces saraciticas as Soil Amendments for Controlling Soil-Borne Plant Pathogens. Plant Pathol. J. 2021, 37, 596. [Google Scholar] [CrossRef]
- Doumbou, C.L.; Hamby, S.; Crawford, D.; Beaulieu, C. Actinomycetes, promising tools to control plant diseases and to promote plant growth. Phytoprotection 2001, 82, 85–102. [Google Scholar] [CrossRef]
- Doumbou, C.; Akimov, V.; Cote, M.; Charest, P.M.; Beaulieu, C. Taxonomic study on nonpathogenic streptomycetes isolated from common scab lesions on potato tubers. Syst. Appl. Microbiol. 2001, 24, 451–456. [Google Scholar] [CrossRef]
- Eccleston, K.L.; Brooks, P.R.; Kurtböke, D.İ. Assessment of the role of local strawberry rhizosphere—Associated Streptomycetes on the bacterially—Induced growth and Botrytis cinerea infection resistance of the fruit. Sustainability 2010, 2, 3831–3845. [Google Scholar] [CrossRef]
- El-Tarabily, K.A.; Sivasithamparam, K. Non-streptomycete actinomycetes as biocontrol agents of soil-borne fungal plant pathogens and as plant growth promoters. Soil Biol. Biochem. 2006, 38, 1505–1520. [Google Scholar] [CrossRef]
- Gopalakrishnan, S.; Srinivas, V.; Prasanna, S. Streptomyces . In Beneficial Microbes in Agro-Ecology; Academic Press: Cambridge, MA, USA, 2020; pp. 55–71. [Google Scholar]
- Hong-Thao, P.T.; Mai-Linh, N.V.; Hong-Lien, N.T.; Van Hieu, N. Biological characteristics and antimicrobial activity of endophytic Streptomyces sp. TQR12-4 isolated from elite Citrus nobilis cultivar Ham Yen of Vietnam. Int. J. Microbiol. 2016, 2016, 7207818. [Google Scholar] [CrossRef]
- Jorjandi, M.; Bonjar, G.S.; Baghizadeh, A.; Sirchi, G.S.; Massumi, H.; Baniasadi, F.; Farokhi, P.R. Biocontrol of Botrytis allii Munn the causal agent of neck rot, the post harvest disease in onion, by use of a new Iranian isolate of Streptomyces. Am. J. Agric. Biol. Sci. 2009, 4, 72–78. [Google Scholar] [CrossRef]
- Taechowisan, T.; Chuaychot, N.; Chanaphat, S.; Wanbanjob, A.; Tantiwachwutikul, P. Antagonistic effects of Streptomyces sp. SRM1 on Colletotrichum musae. Biotechnology 2009, 8, 86–92. [Google Scholar] [CrossRef]
- Thilagam, R.; Hemalatha, N. Plant growth promotion and chilli anthracnose disease suppression ability of rhizosphere soil actinobacteria. J. Appl. Microbiol. 2019, 126, 1835–1849. [Google Scholar] [CrossRef]
- Evangelista-Martnnez, Z. Isolation and characterization of soil Streptomyces species as potential biological control agents against fungal plant pathogens. World J. Microbiol. Biotechnol. 2014, 30, 1639–1647. [Google Scholar] [CrossRef]
- Manikandan, A.; Johnson, I.; Jaivel, N.; Krishnamoorthy, R.; SenthilKumar, M.; Raghu, R.; Gopa, N.O.; Mukherjee, P.K.; Anandham, R. Gamma-induced mutants of Bacillus and Streptomyces display enhanced antagonistic activities and suppression of the root rot and wilt diseases in pulses. Biomol. Concepts 2022, 13, 103–118. [Google Scholar] [CrossRef]
- Shanthi, V. Actinomycetes: Implications and prospects in sustainable agriculture. In Biofertilizers: Study and Impact; Wiley: Hoboken, NJ, USA, 2021; pp. 335–370. [Google Scholar]
- Cordero, I.; Balaguer, L.; Rincon, A.; Pueyo, J.J. Inoculation of tomato plants with selected PGPR represents a feasible alternative to chemical fertilization under salt stress. J. Plant Nutr. Soil Sci. 2018, 181, 694–703. [Google Scholar] [CrossRef]
- Vimal, S.R.; Singh, J.S.; Arora, N.K.; Singh, S. Soil-plant-microbe interactions in stressed agriculture management: A review. Pedosphere 2017, 27, 177–192. [Google Scholar] [CrossRef]
- Pappachan, A.; Rahul, K.; Irene, L.; Sivaprasad, V. Molecular identification of fungi associated with mulberry root rot disease in Eastern and North Eastern India. J. Crop Weed 2020, 16, 180–185. [Google Scholar] [CrossRef]
- Anwar, S.; Ali, B.; Sajid, I. Screening of rhizospheric actinomycetes for various in-vitro and in-vivo plant growth promoting (PGP) traits and for agroactive compounds. Front. Microbiol. 2016, 7, 1334. [Google Scholar] [CrossRef] [PubMed]
- Saadoun, I.; Hameed, K.; Moussauui, A. Characterization and analysis of antibiotic activity of some aquatic actinomycetes. Microbios 1999, 99, 173–179. [Google Scholar]
- Kurtboke, D.I. Selective Isolation of Rare Actinomycetes; Queensland Complete Printing Services: Nambour, Australia, 2003. [Google Scholar]
- Taechowisan, T.; Peberdy, J.; Lumyong, S. Chitinase production by endophytic Streptomyces aureofaciens CMUAc130 and its antagonism against phytopathogenic fungi. Ann. Microbiol. 2003, 53, 447–462. [Google Scholar]
- Harsonowati, W.; Astuti, R.I.; Wahyudi, A.T. Leaf blast disease reduction by rice-phyllosphere actinomycetes producing bioactive compounds. J. Gen. Plant Pathol. 2017, 83, 98–108. [Google Scholar] [CrossRef]
- Li, J.; Zhao, G.Z.; Huang, H.Y.; Qin, S.; Zhu, W.Y.; Zhao, L.X.; Xu, L.H.; Zhang, S.; Li, W.J.; Strobel, G. Isolation and characterization of culturable endophytic actinobacteria associated with Artemisia annua L. Antonie Van Leeuwenhoek 2012, 101, 515–527. [Google Scholar] [CrossRef]
- Kieser, T.; Bibb, M.J.; Buttner, M.J.; Chater, K.F.; Hopwood, D.A. Practical Streptomyces Genetics; John Innes Foundation: Norwich, UK, 2000; Volume 291. [Google Scholar]
- Khamna, S.; Yokota, A.; Lumyong, S. Actinomycetes isolated from medicinal plant rhizosphere soils: Diversity and screening of antifungal compounds, indole-3-acetic acid and siderophore production. World J. Microbiol. Biotechnol. 2009, 25, 649–655. [Google Scholar] [CrossRef]
- Shrivastava, P.; Kumar, R.; Yandigeri, M.S. In vitro biocontrol activity of halotolerant Streptomyces aureofaciens K20: A potent antagonist against Macrophomina phaseolina (Tassi) Goid. Saudi J. Biol. Sci. 2017, 24, 192–199. [Google Scholar] [CrossRef]
- Lee, J.Y.; Hwang, B.K. Diversity of antifungal actinomycetes in various vegetative soils of Korea. Can. J. Microbiol. 2002, 48, 407–417. [Google Scholar] [CrossRef] [PubMed]
- Liotti, R.G.; da Silva Figueiredo, M.I.; Soares, M.A. Streptomyces griseocarneus R132 controls phytopathogens and promotes growth of pepper (Capsicum annuum). Biol. Control 2019, 138, 104065. [Google Scholar] [CrossRef]
- Aneja, K. Experiments in Microbiology, Plant Pathology and Biotechnology; New Age International: New Delhi, India, 2007. [Google Scholar]
- Hankin, L.; Anagnostakis, S.L. Solid media containing carboxymethylcellulose to detect Cx cellulase activity of micro-organisms. Microbiology 1977, 98, 109–115. [Google Scholar] [CrossRef] [PubMed]
- Sadeghian, M.; Bonjar, G.H.S.; Sirchi, G.R.S. Post harvest biological control of apple bitter rot by soil-borne actinomycetes and molecular identification of the active antagonist. Postharvest Biol. Technol. 2016, 112, 46–54. [Google Scholar] [CrossRef]
- Shah, D.; Soni, A. Isolation and screening of actinomycetes from mangrove soil for enzyme production and antimicrobial activity. Int. J. Innov. Sci. Res. 2016, 3, 54. [Google Scholar]
- Sadeghi, A.; Karimi, E.; Dahaji, P.A.; Javid, M.G.; Dalvand, Y.; Askari, H. Plant growth promoting activity of an auxin and siderophore producing isolate of Streptomyces under saline soil conditions. World J. Microbiol. Biotechnol. 2012, 28, 1503–1509. [Google Scholar] [CrossRef]
- Holding, A.; Collee, J. Chapter I Routine biochemical tests. In Methods in Microbiology; Elsevier: Amsterdam, The Netherlands, 1971; Volume 6, pp. 1–32. [Google Scholar]
- Gebily, D.A.; Ghanem, G.A.; Ragab, M.M.; Ali, A.M.; Soliman, N.E.; El-Moity, A.; Tawfik, H. Characterization and potential antifungal activities of three Streptomyces spp. as biocontrol agents against Sclerotinia sclerotiorum (Lib.) de Bary infecting green bean. Egypt. J. Biol. Pest Control 2021, 31, 33. [Google Scholar] [CrossRef]
- Meena, M.; Swapnil, P.; Zehra, A.; Dubey, M.K.; Upadhyay, R. Antagonistic assessment of Trichoderma spp. by producing volatile and non-volatile compounds against different fungal pathogens. Arch. Phytopathol. Plant Prot. 2017, 50, 629–648. [Google Scholar] [CrossRef]
- Sridharan, A.; Thankappan, S.; Karthikeyan, G.; Uthandi, S. Comprehensive profiling of the VOCs of Trichoderma longibrachiatum EF5 while interacting with Sclerotium rolfsii and Macrophomina phaseolina. Microbiol. Res. 2020, 236, 126436. [Google Scholar]
- Passari, A.K.; Mishra, V.K.; Gupta, V.K.; Yadav, M.K.; Saikia, R.; Singh, B.P. In vitro and in vivo plant growth promoting activities and DNA fingerprinting of antagonistic endophytic actinomycetes associates with medicinal plants. PLoS ONE 2015, 10, e0139468. [Google Scholar] [CrossRef]
- El-Sayed, W.S.; Akhkha, A.; El-Naggar, M.Y.; Elbadry, M. In vitro antagonistic activity, plant growth promoting traits and phylogenetic affiliation of rhizobacteria associated with wild plants grown in arid soil. Front. Microbiol. 2014, 5, 651. [Google Scholar] [CrossRef] [PubMed]
- Saratha, M.; Angappan, K.; Karthikeyan, S.; Marimuthu, S.; Chozhan, K. Actinoalloteichus cyanogriseus: A broad spectrum bio-agent against mulberry root rot pathogens. Egypt. J. Biol. Pest Control 2022, 32, 33. [Google Scholar] [CrossRef]
- Samson, R.A.; Stalpers, J.A.; Verkerke, W. A simplified technique to prepare fungal specimens for scanning electron microscopy. Cytobios 1979, 24, 7–11. [Google Scholar] [PubMed]
- Inderiati, S.; Franco, C.M. Isolation and identification of endophytic actinomycetes and their antifungal activity. J. Biotechnol. Res. Trop. Reg. 2008, 1, 1–6. [Google Scholar]
- Gopalakrishnan, S.; Vadlamudi, S.; Bandikinda, P.; Sathya, A.; Vijayabharathi, R.; Rupela, O.; Varshney, R.K. Evaluation of Streptomyces strains isolated from herbal vermicompost for their plant growth-promotion traits in rice. Microbiol. Res. 2014, 169, 40–48. [Google Scholar] [CrossRef] [PubMed]
- Saitou, N.; Nei, M. The neighbor-joining method: A new method for reconstructing phylogenetic trees. Mol. Biol. Evol. 1987, 4, 406–425. [Google Scholar]
- Tamura, K.; Stecher, G.; Kumar, S. MEGA11: Molecular evolutionary genetics analysis version 11. Mol. Biol. Evol. 2021, 38, 3022–3027. [Google Scholar] [CrossRef]
- Cawoy, H.; Debois, D.; Franzil, L.; De Pauw, E.; Thonart, P.; Ongena, M. Lipopeptides as main ingredients for inhibition of fungal phytopathogens by Bacillus subtilis/amyloliquefaciens. Microb. Biotechnol. 2015, 8, 281–295. [Google Scholar] [CrossRef]
- Strobel, G.; Daisy, B.; Castillo, U.; Harper, J. Natural products from endophytic microorganisms. J. Nat. Prod. 2004, 67, 257–268. [Google Scholar] [CrossRef]
- Sudha, A.; Durgadevi, D.; Archana, S.; Muthukumar, A.; Raj, T.S.; Nakkeeran, S.; Poczai, P.; Nasif, O.; Ansari, M.J.; Sayyed, R.Z. Unraveling the tripartite interaction of volatile compounds of Streptomyces rochei with grain mold pathogens infecting sorghum. Front. Microbiol. 2022, 13, 923360. [Google Scholar] [CrossRef]
- Olanrewaju, O.S.; Babalola, O.O. Streptomyces: Implications and interactions in plant growth promotion. Appl. Microbiol. Biotechnol. 2019, 103, 1179–1188. [Google Scholar] [CrossRef] [PubMed]
- Vurukonda, S.S.K.P.; Giovanardi, D.; Stefani, E. Plant growth promoting and biocontrol activity of Streptomyces spp. as endophytes. Int. J. Mol. Sci. 2018, 19, 952. [Google Scholar] [CrossRef] [PubMed]
- Shahbazi, P.; Musa, M.Y.; Tan, G.Y.A.; Avin, F.A.; Teo, W.F.A.; Sabaratnam, V. In vitro and in vivo evaluation of Streptomyces suppressions against anthracnose in chili caused by Colletotrichum. Sains Malays. 2014, 43, 697–705. [Google Scholar]
- Chater, K.F. Streptomyces inside-out: A new perspective on the bacteria that provide us with antibiotics. Philos. Trans. R. Soc. B Biol. Sci. 2006, 361, 761–768. [Google Scholar] [CrossRef] [PubMed]
- Williams, S.; Vickers, J. Detection of actinomycetes in the natural environment: Problems and perspectives. Biol. Actinomycetes 1988, 88, 265–270. [Google Scholar]
- Hyder, S.; Gondal, A.S.; Rizvi, Z.F.; Ahmad, R.; Alam, M.M.; Hannan, A.; Ahmed, W.; Fatima, N.; Inam-ul-Haq, M. Characterization of native plant growth promoting rhizobacteria and their anti-oomycete potential against Phytophthora capsici affecting chilli pepper (Capsicum annum L.). Sci. Rep. 2020, 10, 13859. [Google Scholar] [CrossRef]
- Chaudhry, M.J. Exploring the Biocontrol Potential of Streptomyces isolates Against Pythium violae, a Dominant Carrot Pathogen. Master’s Thesis, California State University, Bakersfield, CA, USA, 2021. [Google Scholar]
- Xu, T.; Cao, L.; Zeng, J.; Franco, C.M.; Yang, Y.; Hu, X.; Bu, Z. The antifungal action mode of the rice endophyte Streptomyces hygroscopicus OsiSh-2 as a potential biocontrol agent against the rice blast pathogen. Pestic. Biochem. Physiol. 2019, 160, 58–69. [Google Scholar] [CrossRef]
- Veliz, E.A.; Martínez-Hidalgo, P.; Hirsch, A.M. Chitinase-producing bacteria and their role in biocontrol. AIMS Microbiol. 2017, 3, 689. [Google Scholar] [CrossRef]
- Jha, S.; Modi, H. Comparative analysis of chitinase activity by four different assay from soil born Actinomycetes. In Proceedings of the 4th International Conference on Multidisciplinary Research and Practice (4ICMRP-2017), Ahmedabad, India, 22 December 2017. [Google Scholar]
- Bhattacharyya, C.; Banerjee, S.; Acharya, U.; Mitra, A.; Mallick, I.; Haldar, A.; Ghosh, A. Evaluation of plant growth promotion properties and induction of antioxidative defense mechanism by tea rhizobacteria of Darjeeling, India. Sci. Rep. 2020, 10, 15536. [Google Scholar] [CrossRef]
- Froes, A.; Macrae, A.; Rosa, J.; Franco, M.; Souza, R.; Soares, R.; Coelho, R. Selection of a Streptomyces strain able to produce cell wall degrading enzymes and active against Sclerotinia sclerotiorum. J. Microbiol. 2012, 50, 798–806. [Google Scholar] [CrossRef]
- Shanmugaiah, V.; Nithya, K.; Harikrishnan, H.; Jayaprakashvel, M.; Balasubramanian, N. Biocontrol mechanisms of siderophores against bacterial plant pathogens. In Sustainable Approaches to Controlling Plant Pathogenic Bacteria; CRC Press: Boca Raton, FL, USA, 2015; pp. 167–190. [Google Scholar]
- Berendsen, R.L.; Pieterse, C.M.; Bakker, P.A. The rhizosphere microbiome and plant health. Trends Plant Sci. 2012, 17, 478–486. [Google Scholar] [CrossRef] [PubMed]
- Wattanasuepsin, W.; Intra, B.; Euanorasetr, J.; Watanabe, Y.; Mingma, R.; Fukasawa, W.; Panbangred, W. 1-Methoxypyrrole-2-carboxamide—A new pyrrole compound isolated from Streptomyces griseocarneus SWW368. J. Gen. Appl. Microbiol. 2017, 63, 207–211. [Google Scholar] [CrossRef] [PubMed]
- Shimizu, M.; Yazawa, S.; Ushijima, Y. A promising strain of endophytic Streptomyces sp. for biological control of cucumber anthracnose. J. Gen. Plant Pathol. 2009, 75, 27–36. [Google Scholar] [CrossRef]
- Ilic, S.; Konstantinovic, S.; Todorovic, Z.; Lazic, M.; Veljkovic, V.; Jokovic, N.; Radovanovic, B. Characterization and antimicrobial activity of the bioactive metabolites in streptomycete isolates. Microbiology 2007, 76, 421–428. [Google Scholar] [CrossRef]
- Rothrock, C.S.; Gottlieb, D. Role of antibiosis in antagonism of Streptomyces hygroscopicus var. geldanus to Rhizoctonia solani in soil. Can. J. Microbiol. 1984, 30, 1440–1447. [Google Scholar] [CrossRef]
- Evangelista-Martinez, Z.; Contreras-Leal, E.A.; Corona-Pedraza, L.F.; Gastelum-Martinez, É. Biocontrol potential of Streptomyces sp. CACIS-1.5 CA against phytopathogenic fungi causing postharvest fruit diseases. Egypt. J. Biol. Pest Control 2020, 30, 117. [Google Scholar] [CrossRef]
- Yasmin, S.; Zaka, A.; Imran, A.; Zahid, M.A.; Yousaf, S.; Rasul, G.; Mirza, M.S. Plant growth promotion and suppression of bacterial leaf blight in rice by inoculated bacteria. PLoS ONE 2016, 11, e0160688. [Google Scholar] [CrossRef]
Disclaimer/Publisher’s Note: The statements, opinions and data contained in all publications are solely those of the individual author(s) and contributor(s) and not of MDPI and/or the editor(s). MDPI and/or the editor(s) disclaim responsibility for any injury to people or property resulting from any ideas, methods, instructions or products referred to in the content. |
© 2023 by the authors. Licensee MDPI, Basel, Switzerland. This article is an open access article distributed under the terms and conditions of the Creative Commons Attribution (CC BY) license (https://creativecommons.org/licenses/by/4.0/).









